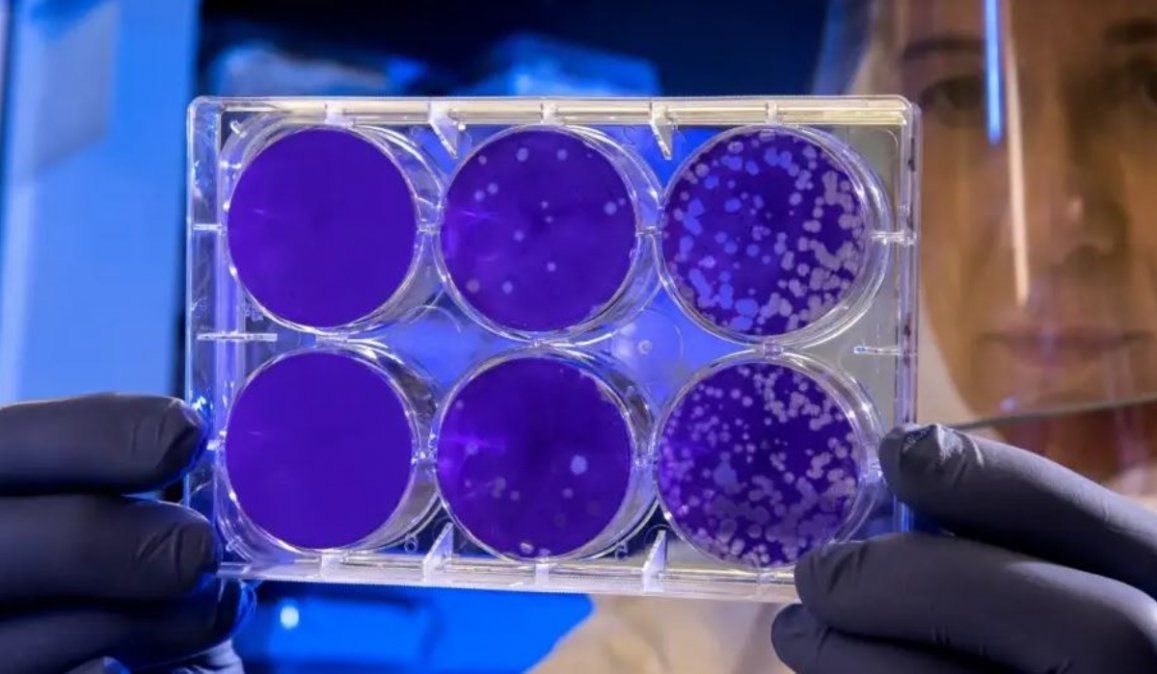

"Covid-22": investigador suizo advierte sobre la posible aparición de una nueva supervariante
"Podría ser incluso peor de lo que estamos experimentando ahora", remarcó Sai Reddy sobre una nueva etapa de la pandemia mucho más peligrosa. "Ya no podremos depender únicamente de las vacunas", aventuró.
"Podría ser incluso peor de lo que estamos experimentando ahora", sostuvo Reddy en una entrevista con el diario local SonntagsBlick. Aclaró además que la nueva cepa llegará a Suiza como a todo el mundo y es por eso que "tenemos que prepararnos".
"Con el correr de los años, recibiremos varias vacunas, que deberán ser adaptadas continuamente", dijo. Señaló que las variantes de coronavirus de Sudáfrica (Beta) y Brasil (Gamma) ya han mutado y evaden parcialmente los anticuerpos.
Con respecto a la variante Delta, mucho más contagiosa, indicó que si bien no ha desarrollado mutaciones hasta ahora, su evolución sería caótica: "Si Delta desarrolla mutaciones, entonces podríamos estar hablando de una nueva fase de la pandemia".
Señaló que los hallazgos científicos recientes muestran que la carga viral de la variante Delta es tan alta que cualquier persona no vacunada que la contraiga puede convertirse en un "super esparcidor". Avaló también la necesidad de una tercera dosis de refuerzo.
En relación al panorama local, Reddy dijo que espera que los nuevos casos de Covid aumenten aún más en Suiza este otoño. “Si la tasa de vacunación no aumenta rápidamente, solo las medidas restrictivas severas pueden evitar que ocurra lo peor”, anticipó.
"Serán seis meses muy duros. El verano de 2021 se sintió como 2019. Pero los próximos otoño e invierno serán como el año pasado. Esto se debe a la variante delta y al hecho de que no podemos controlarla bajo ningún concepto", lamentó a continuación.
Y concluyó: "El virus y nuestro sistema inmunológico ahora están estrechamente relacionados, como dos bailarines: el sistema inmunológico se mueve y el virus reacciona. Bailaremos con él durante mucho tiempo. Tal vez por el resto de nuestras vidas".
Desde finales de junio, el número de nuevas infecciones por coronavirus reportadas ha aumentado en Suiza. Las admisiones hospitalarias también están aumentando, pero la tasa de mortalidad sigue siendo baja. más del 50% de la población está vacunada.
El aumento de nuevos casos se debe en gran parte a la cepa de la India que afecta a personas no vacunadas, principalmente en el grupo de edad de 10 a 29 años. Tanja Stadler, directora del grupo de trabajo científico Covid-19 dijo que la situación es "muy difícil".
Suiza registró 2989 nuevos casos y 6 muertes el martes 24 de agosto, en una población de 8.5 millones. Desde el inicio de la pandemia de coronavirus, el país europeo tuvo un total de 709.536 contagios junto con 10.379 pérdidas de vidas humanas.